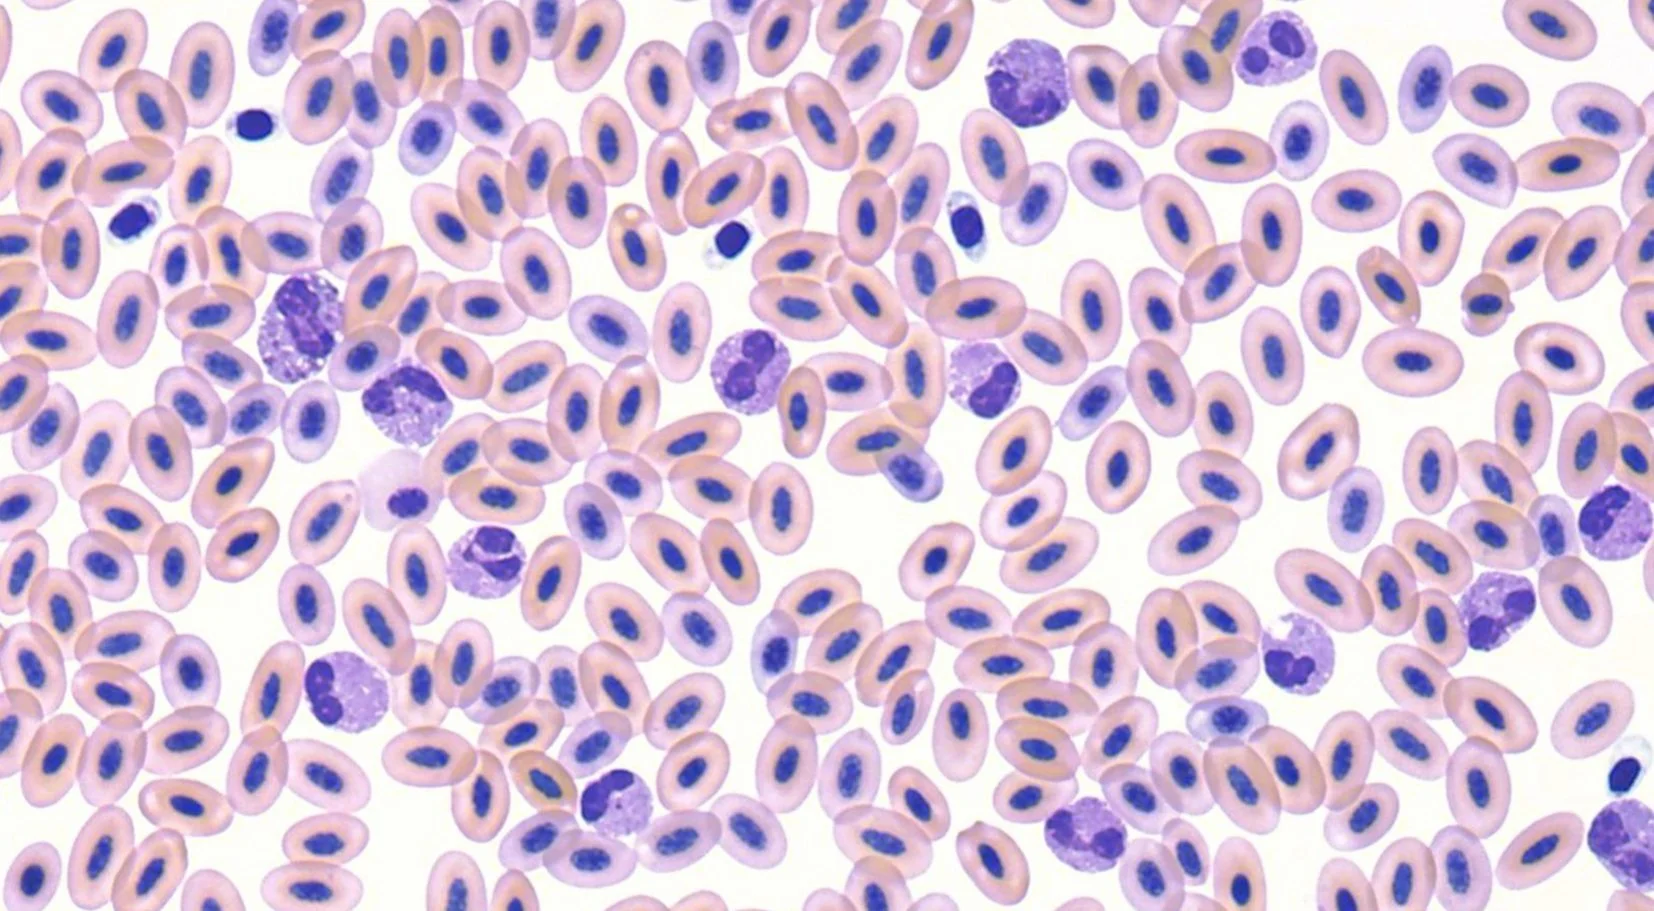
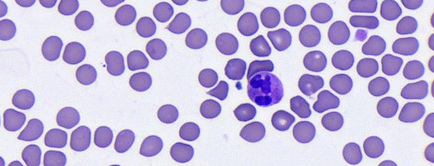

Veterinary diagnostics
Fast. Precise. Affordable.

Pathview
AI-assisted hematology and cytology system in your clinic.
.
Save
more time
15 min
Preliminary results
.
Save
more costs
35%+
Average savings
.
Save
more patients
57%+
Abnormality detected

Save
more with Moichor
.
“Like having pathologists in your clinic”
Pathologist-level results, assisted by AI, right in your clinic.
Results in as little as 15 minutes.
Perform CBC and cytology evaluation for any species.
Early disease detection for better patient outcomes.
Improve ROI with in-house diagnostics.


Trusted by leading clinics





.
More information?
Our team will get back to you with details on how our system can transform your veterinary diagnostics.
.
Request demo
Discover how Pathview can enhance your in-clinic diagnostics with faster, more accurate results to elevate the level of care you provide.
.
Pathview details
Learn more about Pathview’s capabilities and see how it streamlines in-clinic diagnostics.